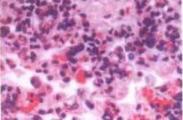
奇孔古尼亞病毒性疾病

奇孔古尼亞病毒性疾病是由奇孔古尼亞熱病毒引起的,經蚊蟲叮咬傳播的急性感染性疾病。臨床上以發熱、皮疹、出血、關節劇痛為特征,少數患者遺留持續性關節僵硬。
- 外文名:
- 就診科室:兒科
- 傳染性:有
- 多發群體:
- 常見病因:
- 常見癥狀:斑丘疹、齒齦出血、充血、出血傾向、惡心、腹痛、腹瀉、關節疼痛
- 人氣指數: 人
- 更新日期:2023.12.05 14:29
- 疾病介紹
疾病標簽:
-
奇孔古尼亞病毒性疾病,奇孔古尼亞病毒性疾病癥
版權聲明:
1、本站內容僅做參考,不能作為診斷及醫療的依據!
2、本文內容來源于網絡或會員發布,版權歸原網站所有。
3、本站僅提供信息展示,不承擔相關法律責任。





